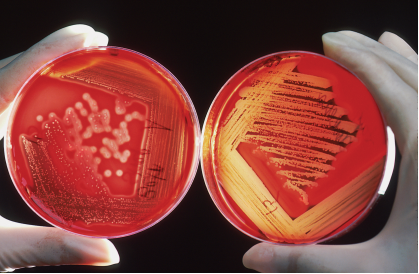

“¿Qué es la investigación? Una respuesta razonablemente precisa podría ser: ‘Búsqueda enfocada y sistemática dirigida a generar nuevo conocimiento’. Esta definición puede ayudarte a distinguir la investigación genuina (que debería informar tu práctica) de los esfuerzos de baja calidad de aficionados bien intencionados (a los cuales deberías ignorar amablemente)”.
-Trisha Greenhalgh1
Existen dudas con las que todos los profesionales de la salud, en su práctica clínica, se toparán en algún momento: ¿Este paciente realmente tiene una enfermedad crónica (e. g. hipertensión) y debería de iniciar una terapia a largo plazo? ¿Cuál intervención es la mejor que se le puede ofrecer al paciente? ¿Cómo evolucionará la enfermedad una vez que inicie tratamiento? ¿Cuáles son los posibles efectos indeseables de los tratamientos? Entre muchas otras.
Para todos los profesionales de la salud, se considera a la actualización continua como una parte indispensable del buen ejercicio, la cual puede ayudar a resolver mejor algunas preguntas como las mencionadas. Se podría incluso argumentar que es uno de los requisitos indispensables en la búsqueda de la excelencia al desempeñar la profesión. Sin embargo, actualizarse parece una tarea titánica cuando uno se da cuenta de la cantidad de información disponible. De tal forma que, si bien existen diversas estrategias para abordar dicha actualización, la búsqueda de la mejor evidencia disponible puede ayudar a tomar mejores decisiones. Pero, para ello, es necesario comprender plenamente de qué hablamos cuando hablamos de evidencia.
Además, el entendimiento de los niveles de evidencia en la investigación clínica es crucial para una comunicación efectiva entre los profesionales de la salud.
EVIDENCIA CIENTÍFICA
La evidencia científica se origina a partir de estudios de investigación que aportan información sobre un tema específico en un momento determinado. Estos estudios se desarrollan siguiendo el método científico y aplicando la medicina clínica para realizar diagnósticos, determinar pronósticos y aplicar tratamientos a pacientes individuales2. Cada año, se publican más de dos millones de artículos biomédicos, lo que dificulta su análisis y su utilización para mejorar o actualizar las estrategias médicas. Por ello, una habilidad clave es la evaluación crítica de los estudios: analizar su consistencia y validez, determinar si sus resultados pueden generalizarse o si varían según los distintos grupos de población, y así obtener conclusiones y evidencias de calidad. En muchos casos, como señala la cita inicial de este artículo, es igual de importante saber qué información no es útil y descartarla.
Para facilitar esta serie de tareas, se ha establecido una jerarquía de la evidencia que ayuda a clasificar los estudios disponibles3.
PIRÁMIDE DE LA EVIDENCIA
La pirámide de la evidencia en salud es una representación gráfica que organiza los diferentes tipos de estudios y fuentes de información de acuerdo con su nivel de validez científica y confiabilidad. Un ejemplo se observa en la figura 1, donde se ilustra una pirámide de evidencia que es útil para evaluar el diseño en estudios de intervención. Esta pirámide ha sido y sigue siendo utilizada principalmente en medicina basada en la evidencia (MBE) para guiar a los profesionales de la salud en la toma de decisiones clínicas4.

Figura 1 Una jerarquía sencilla de la evidencia para evaluar la calidad del diseño de los estudios de intervenciones terapéuticas. Adaptado de Greenhalgh, T. 2019
Los niveles más altos de la pirámide representan tipos de evidencia que son considerados más robustos, mientras que los niveles más bajos incluyen estudios que, aunque valiosos, tienen un mayor riesgo de sesgo5. Dentro de los objetivos de la pirámide de la evidencia, además de clasificar los estudios, se busca garantizar que los investigadores, clínicos y trabajadores de la salud proporcionen a cada individuo una atención de excelencia en la toma de decisiones, basada en la mejor evidencia científica disponible6.
MEDICINA BASADA EN LA EVIDENCIA
El movimiento de la MBE surgió en la década de 1980 y obedecía a la necesidad de mejorar la calidad de la atención médica, que, hasta ese momento, estaba basada en gran medida en la experiencia clínica individual, la formación médica recibida, la intuición y la tradición. En el siglo XX, la investigación médica tuvo un crecimiento importante, con nuevos descubrimientos y el desarrollo de métodos en investigación clínica y estadística. Estos avances llevaron a un vasto crecimiento de la literatura médica, que no siempre tenía la misma calidad. Se hizo, cada día más difícil para los profesionales de la salud estar actualizados e integrar el nuevo conocimiento en su práctica diaria, y fue evidente que no siempre se utilizaba la mejor evidencia científica en la práctica clínica5.
El término medicina basada en la evidencia (MBE) fue acuñado y popularizado por dos destacados científicos de la Universidad de McMaster, en Hamilton, Ontario, Canadá: David Sackett, considerado el padre de la MBE, y Gordon Guyatt. La MBE se define como “la integración de la mejor evidencia de investigación con la experiencia clínica y los valores del paciente”. Además, se incluye la práctica clínica en la evidencia, considerando el entorno de la atención médica y las circunstancias específicas de la práctica médica7.
En dicha universidad, en el Departamento de Epidemiología Clínica (el primero en el mundo en llevar ese nombre), se hizo énfasis en utilizar la evidencia para la atención de pacientes individuales. En esta área surgieron las primeras guías sobre cómo leer, evaluar y apreciar los artículos médico 8-12, utilizando diferentes estándares metodológicos para cada uno de los diversos tipos de diseños clásicos que pueden observarse en la pirámide de la evidencia.
De acuerdo con los estándares metodológicos de los diseños de estudio, existe una clasificación según el control de variables y el manejo de datos, por lo que se dividen en estudios primarios, secundarios y, más recientemente, terciarios.
Los estudios primarios incluyen diseños experimentales, como los ensayos clínicos aleatorizados, y diseños observacionales, como los estudios de cohortes, caso-control y transversales. Estos proporcionan datos directos y primarios necesarios para valorar intervenciones específicas13.
Los estudios secundarios o de resumen incluyen a las revisiones sistemáticas y los metaanálisis, que sintetizan la evidencia primaria. Esto es fundamental para la toma de decisiones clínicas, ya que permite evaluar la fortaleza y consistencia de los hallazgos a partir de múltiples estudios individuales.
Finalmente, los estudios terciarios abarcan resúmenes de temas amplios dirigidos a tomadores de decisiones y directivos médicos13.
Dentro de los estudios secundarios, es importante destacar a las guías de práctica clínica (GPC), que son cruciales para la práctica médica basada en evidencia. Estas guías integran revisiones sistemáticas y análisis económicos para ofrecer recomendaciones fundamentadas en evidencia robusta. Su objetivo es proporcionar a los clínicos pautas específicas para el manejo de situaciones clínicas comunes, basadas en la mejor evidencia disponible13,14.
Por último, los estudios terciarios dirigidos a tomadores de decisiones y directivos médicos, como la revisión de un área terapéutica específica. Estos estudios sintetizan la información existente y ayudan a identificar brechas en la evidencia, así como a formular recomendaciones basadas en la mejor información disponible13.
Los diseños clásicos son esenciales en la investigación clínica y en el método epidemiológico, y se organizan jerárquicamente según su capacidad para limitar sesgos y proporcionar evidencia confiable15.
NIVELES DE LA PIRÁMIDE DE LA EVIDENCIA4,6
En la base de la pirámide de la evidencia (figura 1) se encuentran los estudios de menor evidencia, que incluyen:
-
Opiniones de expertos, revisiones narrativas y reportes de casos.Estos tipos de estudios se basan en la experiencia de expertos, comentarios, editoriales y reportes de casos individuales. No siguen una metodología sistemática, lo que implica un alto riesgo de sesgo. Aunque son útiles para proporcionar el contexto o las experiencias anecdóticas, su validez científica es limitada.
A medida que se asciende en los niveles de la pirámide, se encuentran estudios originales necesarios para valorar intervenciones específicas. Estos estudios corresponden, por su tipo de diseño, a investigaciones observacionales, como:
Estudios transversales. Permiten explorar o describir un tema y sus posibles factores relacionados con la ocurrencia de una condición determinada en un grupo de sujetos. Sin embargo, es importante destacar que estos estudios no establecen relaciones de causalidad.
Estudios de casos y controles. Comparan a personas con una condición particular (casos) con aquellas que no la tienen (controles). Su objetivo es buscar exposiciones previas para estudiar enfermedades raras de forma retrospectiva.
Estudios de cohortes. A diferencia de los estudios de casos y controles, los estudios de cohortes observan a grupos de personas a lo largo del tiempo. Este diseño permite establecer relaciones más claras entre la exposición y el efecto al evaluar la temporalidad de los eventos.
Estudios de intervención. Incluye ensayos clínicos sin grupo de comparación o sin aleatorización, que no pueden considerarse en la siguiente categoría, pero pueden aportar puntos de vista acerca de la intervención evaluada.
-
Ensayos clínicos controlados y aleatorizados (ECAs). Son estudios experimentales en los cuales los participantes reciben diferentes intervenciones o tratamientos. La aleatorización se refiere a que existe una metodología específica que asigna a los participantes de forma aleatoria a grupos de tratamiento. Los ECAs son considerados una de las formas más confiables de evidencia debido a la reducción de sesgos y proporcionar resultados más robustos sobre la eficacia de los tratamientos.
En la cima de la pirámide se encuentran:
-
Revisiones sistemáticas, metaanálisis, estudios de costos y guías de práctica clínica.Todos estos diseños se consideran estudios de resumen o de investigación secundaria, ya que utilizan la investigación previamente publicada como base para análisis y el desarrollo de nuevas preguntas de investigación, o para resumir la información en salud de acuerdo con criterios metodológicos.
Las revisiones sistemáticas sintetizan y analizan todos los estudios relevantes sobre una pregunta de investigación específica, mientras que los metaanálisis combinan los resultados de varios estudios para proporcionar una estimación global del efecto de una intervención. Estos tipos de estudios se consideran los más confiables porque se basan en un análisis exhaustivo de la mejor evidencia disponible.
Las guías de práctica clínica incluyen recomendaciones para proporcionar pautas específicas para el manejo de situaciones clínicas comunes, fundamentadas en la mejor evidencia disponible.
Es importante que, para que las revisiones sistemáticas y los metaanálisis se consideren de alta calidad, deben realizarse de manera meticulosa, utilizando una metodología clara y rigurosa.
Las revisiones sistemáticas con métodos meticulosos son fundamentales para ofrecer una visión clara sobre las intervenciones médicas, evaluando efectivamente su eficacia y posibles efectos adversos14,15.
La pirámide de la evidencia es una herramienta ampliamente utilizada por estudiantes de diversas áreas de las ciencias de la salud, tanto a nivel de pregrado como de posgrado, durante la práctica clínica. Esto permite brindar atención individualizada al paciente y considerando las prácticas de la epidemiología clínica. Por ello, es necesario conocer los métodos de evaluación de la evidencia15.
BREVE CRONOLOGÍA, CLASIFICACIÓN Y MÉTODOS DE EVALUACIÓN DE LA EVIDENCIA
Existen múltiples propuestas y jerarquizaciones para clasificar la evidencia. Manterola y colaboradores, en 2014, realizaron una revisión de la literatura para describir las clasificaciones más utilizadas de la evidencia en el ámbito de la salud.
Uno de los primeros sistemas fue propuesto por la U.S. Preventive Services Task Force (USPSTF), constituido por un grupo de expertos en prevención y MBE que se formó en 1984. Este grupo, enfocado en la investigación realizada en EUA, desarrolló una jerarquización que incluye el nivel de certeza para el beneficio neto de los servicios preventivos, definido como beneficio menos daño. En este contexto, el nivel de certeza puede ser alto, moderado o bajo, considerando los efectos de la prevención en salud. Para ello utiliza grados de recomendación de certeza que van de la A a la l, donde A indica una recomendación con alto grado de certeza y un beneficio neto sustancial, mientras que el grado I no se puede recomendar16.
La clasificación de Sackett (1989), de la Universidad de McMaster como se mencionó previamente, establece niveles de evidencia que van del 1 al 5, donde el nivel 1 representa “la mejor evidencia” y el nivel 5 la “peor o la menos buena “. Estos niveles se fundamentan en los resultados de acuerdo con tipo de estudio, que incluye terapia, prevención, etiología y daño, así como estudios de pronóstico, diagnóstico y económicos. Por ejemplo, se evalúan aspectos del diseño del estudio, el enmascaramiento, los datos estadísticos y las comparaciones entre grupos. Sin embargo, una desventaja principal de esta clasificación es que no contempla diseños de estudios menos robustos, como los transversales o poblacionales16.
El Grading of Recommendations Assessment, development and Evaluation (GRADE), propuesto en el año 2000, clasifica la calidad de la evidencia y la fuerza de las recomendaciones en diferentes contextos clínicos. Este sistema se centra en evaluar la evidencia para una medida de resultado específico basado en varios estudios primarios, considerando de manera sistemática tanto los beneficios como los riesgos asociados a las intervenciones16.
El Centre for Evidence-Based Medicine de Oxford (CEBM) (2009) evalúa la evidencia según el tipo de diseño para diferentes escenarios clínicos, incluyendo tratamientos, prevención, etiología y daño, pronóstico e historia natural, diagnóstico, diagnóstico diferencial y prevalencia, así como estudios económicos y de análisis de decisión. Además, incluye revisiones sistemáticas y considera las pruebas de tamizaje. En su versión más actualizada de 2011, se incorporan preguntas clave que los clínicos pueden formularse, tales como: ¿Qué tan común es el problema? ¿Es precisa la prueba diagnóstica? ¿La intervención ayudará al paciente? Se identifica el diseño del estudio; sin embargo, la autora señala que la desventaja de esta clasificación es que no existen subcategorías que evalúen la calidad de los estudios, lo que puede sesgar el valor a la evidencia16.
Entre los niveles de evidencia que mencionan se encuentra la clasificación del grupo de la Canadian Task Force on Preventive Health Care (CTFPHC), que desde 1994 ha desarrollado guías de práctica clínica en salud preventiva. Esta clasificación incluye 3 niveles: I, ll-1, ll-2, ll-3 y lll, los cuales se basan en el diseño de los estudios y la validez interna16.
Asimismo, la iniciativa del National Institute for Health and Clinical Excellence (NICE), en el Reino Unido se centra en la evaluación de la evidencia de diversos escenarios clínicos. Este organismo considera no solo la evidencia científica, sino también la experiencia del paciente, así como estudios cualitativos, encuestas transversales y guías clínicas. NICE utiliza el sistema GRADE para evaluar estudios de terapia y procedimientos de tratamiento. NICE evalúa la evidencia de estudios de diagnóstico mediante la herramienta QUADAS-2 y los estudios de pronóstico a través de una lista de chequeo ad-hoc. En sus guías clínicas, emplea el instrumento AGREE II para asegurar la aplicabilidad de las recomendaciones16.
Además de NICE, existen otros grupos que también clasifican la evidencia, tales como:
El National Health and Medical Research Council (NHMRC) de Australia.
El Practicing Chiropractors’ Committee on Radiology Protocols (PCCRP), que desarrolla guías de práctica clínica.
La American Diabetes Association (ADA), enfocada en la difusión de normas de atención y directrices sobre diabetes mellitus.
El American College of Cardiology Foundation/American Heart Association Task Force on Practice Guidelines (ACCF/AHA), que actualiza directrices para enfermedades cardiovasculares16.
La pirámide de la evidencia puede tener limitantes observadas en los estudios que se encuentran en la cima, como las revisiones sistemáticas y los ensayos controlados aleatorizados.
LIMITANTES DE LA PIRÁMIDE DE LA EVIDENCIA
Como cualquier herramienta empleada para realizar evaluaciones, la idea de la pirámide de la evidencia tiene limitaciones. Por ejemplo, pese a estar en la parte superior, las revisiones sistemáticas pueden ser susceptibles de sesgos importantes, especialmente con relación a los criterios de inclusión y la metodología empleada, lo que puede generar sesgos de los resultados. Además, los metaanálisis también están sujetos a errores humanos que pueden afectar su validez y a la calidad de los estudios primarios.
Pasando al siguiente escalón, los ensayos clínicos controlados aleatorizados han sido considerados como el estándar de oro en la investigación clínica debido a la alta calidad de su metodología. Estos deben evaluarse detalladamente, ya que, a pesar de ser considerados como los que tienen el mejor diseño, pueden tener algunas limitaciones, como la poca generalización de sus resultados por realizarse en poblaciones homogéneas. El cegamiento, que es común en ensayos clínicos de fármacos, a menudo excluye estudios relacionados con la fisioterapia o la rehabilitación ya que no pueden enmascararse las intervenciones.
En estos diseños, no se consideran adecuadamente los valores y las expectativas de los pacientes, aspectos que son fundamentales en el cuarto paso de la MBE, que implica integrar la evidencia con la experiencia del profesional y las expectativas del paciente. Las decisiones clínicas deben ser tomadas en conjunto entre el médico y el paciente, lo que hace que el uso de la pirámide de la evidencia para seleccionar un tipo de estudio para sugerir un tratamiento es bastante limitado.
Para abordar estas limitaciones, se han propuesto diseños pragmáticos que reflejan la intervención en un contexto de “mundo real”, lo que favorece la validez externa. Asimismo, los diseños factoriales permiten comparar modalidades combinadas y examinar los efectos de interacción entre diferentes tratamientos17.
En algunas ocasiones pueden existir consideraciones éticas que impidan la realización de ensayos clínicos controlados, o bien, los estudios de cohorte suelen ser prolongados y costosos, lo que puede limitar su viabilidad. Por lo tanto, es posible que la mejor evidencia disponible provenga de otros tipos de diseños experimentales que, aunque diferentes, pueden ofrecer información relevante y útil para la práctica clínica.
Considerando las limitantes de la rigidez de los estudios en la pirámide de la evidencia tradicional con el tiempo se ha modificado en su estructura como puede verse en la figura 2.

Figura 2 Nueva pirámide de la evidencia. Las divisiones se vuelven menos rígidas y se vuelve tan importante evaluar la calidad del estudio como el tipo de diseño. Adaptado de Murad MH, Asi N, Alsawas M, et al. 2016
Esta nueva versión de la pirámide de la evidencia muestra el cambio de las líneas rígidas por líneas onduladas donde lo que trata de ejemplificar es un enfoque diferente en la misma jerarquización18. Este modelo de pirámide se enfoca en la validez interna y externa de los estudios. La validez interna se evalúa considerando la metodología y el riesgo de sesgo, mientras que la validez externa se refiere a la aplicabilidad de los resultados en contextos clínicos reales18.
Adicionalmente, algunas versiones proponen una jerarquía que incluye diferentes tipos de evidencia, desde estudios individuales hasta sinopsis, síntesis y resúmenes. Esta jerarquía destaca que las evidencias de menor nivel son más difíciles de identificar y evaluar, requiriendo mayor experiencia por parte investigador. Murad y colaboradores también mencionan que, aunque las revisiones sistemáticas y el metaanálisis se encuentran en la parte superior de la pirámide, enfrentan barreras metodológicas, como la heterogeneidad que puede limitar su interpretación. Asimismo, las revisiones sistemáticas presentan dilemas metodológicos que generan incertidumbre.
En este contexto, se sugieren modificaciones visuales a la pirámide clásica de la evidencia. El remplazo de las líneas rectas está inspirado en el enfoque de GRADE, reemplazan las líneas rectas que separan a los diseños de estudio por líneas ondulada, permitiendo una evaluación más dinámica de la calidad de la evidencia en ambas direcciones (arriba y debajo de los dominios de la calidad de la evidencia)18.
Una segunda modificación propone eliminar las revisiones sistemáticas de los niveles más altos de la pirámide, sugiriendo que tanto el metaanálisis como las revisiones sistemáticas deben ser considerados como herramientas para evaluar y aplicar a otros tipos de estudios, teniendo en cuenta el proceso de selección y el análisis estadístico que puede influir en los resultados. Esta nueva versión de la pirámide permite una mejor comprensión del progreso de la MBE y puede ser una herramienta de enseñanza de profesores de MBE para explicar la evaluación de la certeza de la evidencia y su aplicación en la práctica clínica18.
CONCLUSIONES
Es fundamental conocer y utilizar a la pirámide de la evidencia como una herramienta que permite a los profesionales de la medicina tomar mejores decisiones junto con sus pacientes a través de la jerarquización de la evidencia generada en los estudios científicos.
Es importante conocer que no todos los problemas de salud pueden responderse a través de los ensayos clínicos, que son la mejor alternativa para la elección de los tratamientos farmacológicos, pero, por otro lado, los estudios observacionales como las cohortes pueden ser tan importantes para definir causalidad cuando no se puede realizar un ensayo clínico.
Otras de las ventajas que aporta esta pirámide de la evidencia es el preservar y mejorar la calidad de la atención del paciente, favorecer una comunicación científica mediante la evaluación crítica de la evidencia por parte de profesionales de la salud, (médicos, enfermeras, nutricionistas, biólogos, químicos farmacéuticos etc.).
En la actualidad la incorporación de nuevas tecnologías como la inteligencia artificial en el manejo de datos puede aumentar la eficiencia y la calidad en el desarrollo de los diferentes diseños de los estudios clínicos. La integración de estos avances, junto con la metodología de la pirámide de la evidencia es fundamental en la formación de los profesionales de la salud para garantizar que siempre utilicen la mejor evidencia disponible en la atención individual de sus pacientes. Esto resultará en una atención más precisa y mejorada en situaciones tanto preventivas como críticas optimizando su aplicación en la práctica clínica.











 nova página do texto(beta)
nova página do texto(beta)